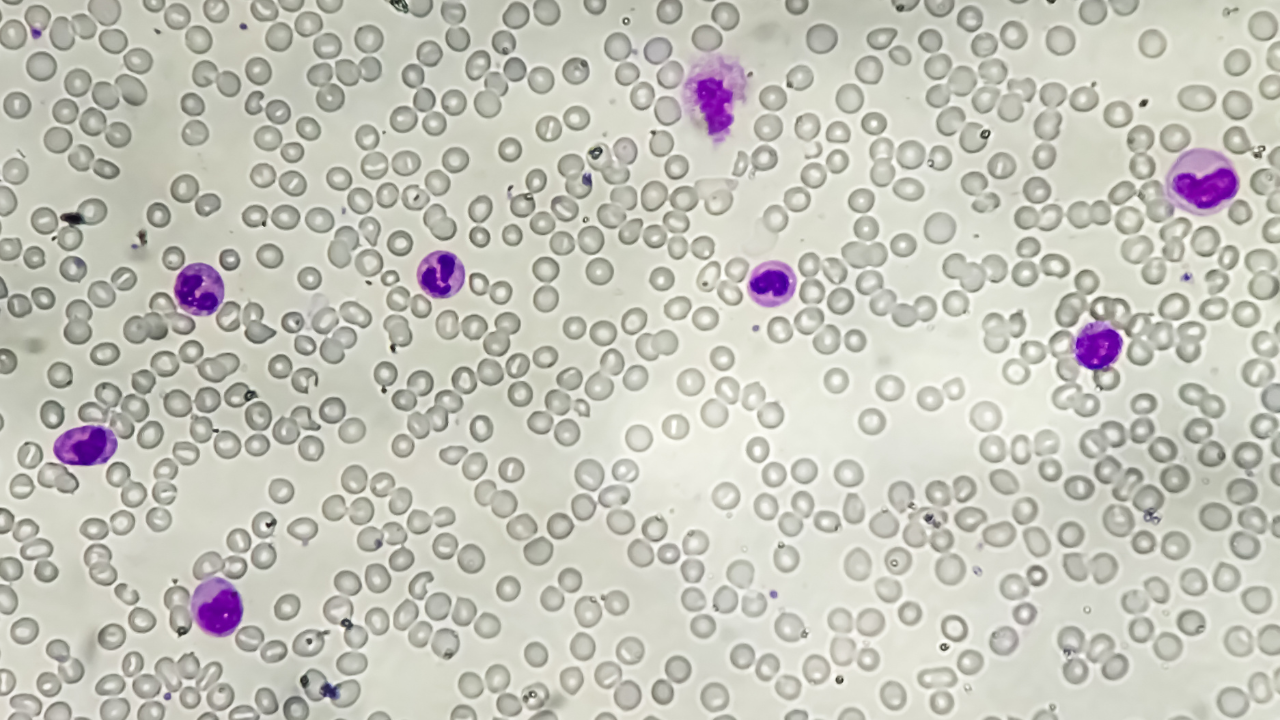
xet-nghiem-xuat-huyet-giam-tieu-cau-la-gi-va-khi-nao-can-thuc-hien.png

Máu đóng vai trò quan trọng trong việc duy trì sự sống, không chỉ vận chuyển oxy và dưỡng chất mà còn giúp cơ thể chống lại các tác nhân gây bệnh. Trong đó, tiểu cầu là thành phần không thể thiếu giúp đông máu và ngăn ngừa chảy máu. Khi số lượng tiểu cầu giảm bất thường, cơ thể sẽ gặp phải tình trạng gọi là xuất huyết giảm tiểu cầu, dễ dẫn đến chảy máu, bầm tím hoặc thậm chí các biến chứng nguy hiểm.
Xét nghiệm xuất huyết giảm tiểu cầu là gì?
Máu là một thành phần quan trọng của cơ thể, bao gồm huyết tương và các tế bào máu như hồng cầu, bạch cầu và tiểu cầu. Trong đó, tiểu cầu đóng vai trò thiết yếu trong quá trình đông máu, giúp cầm máu khi cơ thể gặp chấn thương hoặc vết thương nhỏ, đồng thời ngăn ngừa mất máu quá mức. Khi lượng tiểu cầu trong máu giảm thấp, cơ thể sẽ trở nên dễ chảy máu, ngay cả khi chỉ bị va chạm nhẹ, và nguy cơ biến chứng có thể tăng cao.

Một trong những nguyên nhân gây giảm tiểu cầu là hiện tượng miễn dịch bất thường. Khi cơ thể bị virus, vi khuẩn hoặc ký sinh trùng xâm nhập, hệ miễn dịch sẽ sản sinh ra các kháng thể để tiêu diệt các tác nhân gây hại. Tuy nhiên, trong một số trường hợp, hệ miễn dịch bị rối loạn và nhầm lẫn, tấn công các tế bào bình thường của cơ thể, trong đó có tiểu cầu. Hiện tượng này dẫn đến việc kháng thể gắn vào tiểu cầu và phá hủy chúng, khiến số lượng tiểu cầu trong máu giảm đáng kể. Tình trạng này được gọi là xuất huyết giảm tiểu cầu miễn dịch (Immune Thrombocytopenia, ITP). Bệnh có thể xuất hiện ở mọi lứa tuổi, từ trẻ em đến người lớn, và thường diễn tiến âm thầm, không có triệu chứng rõ ràng ban đầu.
Vì nhiều người bệnh không nhận thấy bất kỳ dấu hiệu nào như chảy máu cam, bầm tím, xuất huyết dưới da hay nướu chảy máu, việc xét nghiệm máu định kỳ trở nên rất quan trọng để phát hiện sớm tình trạng giảm tiểu cầu. Xét nghiệm này giúp đánh giá số lượng tiểu cầu trong máu, xác định xem mức tiểu cầu có thấp bất thường hay không và từ đó hỗ trợ bác sĩ chẩn đoán chính xác. Trong nhiều trường hợp, xét nghiệm bổ sung như kiểm tra các yếu tố đông máu, kháng thể chống tiểu cầu, hoặc xét nghiệm tủy xương có thể được chỉ định để xác định nguyên nhân và mức độ bệnh.
Phát hiện sớm tình trạng giảm tiểu cầu nhờ xét nghiệm là yếu tố then chốt để ngăn ngừa các biến chứng nguy hiểm như chảy máu nặng, xuất huyết nội tạng, hoặc thậm chí đe dọa tính mạng. Bác sĩ sẽ dựa trên kết quả xét nghiệm để đưa ra phương pháp điều trị phù hợp, có thể bao gồm thuốc ức chế miễn dịch, corticosteroid, hoặc các biện pháp can thiệp y tế khác để ổn định lượng tiểu cầu và bảo vệ sức khỏe người bệnh.
Tóm lại, xét nghiệm xuất huyết giảm tiểu cầu là công cụ quan trọng giúp phát hiện sớm tình trạng thiếu hụt tiểu cầu, từ đó hỗ trợ điều trị kịp thời, giảm nguy cơ chảy máu và các biến chứng nguy hiểm. Việc nhận thức về xét nghiệm này cũng góp phần nâng cao cảnh giác của người dân, đặc biệt những người có nguy cơ cao mắc bệnh tự miễn hoặc tiền sử giảm tiểu cầu, để bảo vệ sức khỏe một cách chủ động và an toàn.
Các xét nghiệm xuất huyết giảm tiểu cầu
Khi nghi ngờ mắc bệnh xuất huyết giảm tiểu cầu, việc thực hiện các xét nghiệm chẩn đoán là bước quan trọng để xác định mức độ giảm tiểu cầu, đánh giá tình trạng sức khỏe tổng thể và tìm ra nguyên nhân gây bệnh. Hiện nay, bác sĩ thường chỉ định một số xét nghiệm chính, kết hợp với xét nghiệm bổ sung nếu cần, nhằm cung cấp thông tin đầy đủ cho quá trình chẩn đoán và điều trị.
Xét nghiệm tổng phân tích máu tế bào ngoại vi
Đây là xét nghiệm cơ bản nhưng vô cùng quan trọng trong chẩn đoán xuất huyết giảm tiểu cầu. Mẫu máu được lấy từ tĩnh mạch, sau đó máy xét nghiệm sẽ phân tích và cung cấp số liệu về các thành phần tế bào máu. Qua xét nghiệm này, bác sĩ có thể đánh giá:
- Số lượng tiểu cầu: Xác định mức độ giảm tiểu cầu trong máu, yếu tố quan trọng để quyết định nguy cơ chảy máu và mức độ nặng của bệnh.
- Số lượng hồng cầu và huyết sắc tố: Giúp phát hiện thiếu máu, đánh giá khả năng vận chuyển oxy trong máu.
- Số lượng bạch cầu và công thức bạch cầu: Theo dõi phản ứng miễn dịch, giúp phát hiện nhiễm trùng hoặc các rối loạn khác liên quan đến hệ miễn dịch.
Xét nghiệm tủy đồ
Xét nghiệm tủy đồ là xét nghiệm chuyên sâu nhằm quan sát trực tiếp tủy xương, nơi sản xuất các tế bào máu, bao gồm tiểu cầu, hồng cầu và bạch cầu. Bác sĩ sẽ rút một mẫu dịch tủy xương, thường từ xương chậu, và soi dưới kính hiển vi để đánh giá. Do thao tác này có thể gây đau, nên bệnh nhân thường được gây tê tại chỗ.
Xét nghiệm tủy đồ cung cấp nhiều thông tin quan trọng, bao gồm:
- Phát hiện tế bào ác tính nếu có, loại trừ ung thư máu hoặc các bệnh lý ác tính khác.
- Đánh giá sự phát triển của dòng hồng cầu và bạch cầu, xem xét chúng có bình thường hay bị rối loạn.
- Theo dõi mật độ tế bào tủy, giúp nhận định khả năng tạo tiểu cầu của tủy xương.
- Xác định số lượng tiểu cầu trong tủy, từ đó đánh giá nguyên nhân gây giảm tiểu cầu: Do tủy sản xuất kém hay do bị phá hủy ngoài tủy.

Một số xét nghiệm bổ sung khác
Ngoài các xét nghiệm cơ bản, bác sĩ có thể yêu cầu thêm các xét nghiệm để tìm nguyên nhân cụ thể hoặc phân biệt xuất huyết giảm tiểu cầu với các bệnh lý khác:
- Xét nghiệm vi sinh: Bao gồm Anti-HIV, HBsAg, Anti-HCV để loại trừ các nhiễm trùng virus mạn tính.
- Xét nghiệm miễn dịch: Như ANA, TSH, FT3, FT4, LE cell, giúp phát hiện các bệnh tự miễn hoặc rối loạn nội tiết.
- Xét nghiệm bổ sung nếu có kèm thiếu máu: Hồng cầu lưới, sắt huyết thanh, LDH, Ferritin, Bilirubin,… nhằm đánh giá dự trữ sắt, quá trình phá hủy hồng cầu và tình trạng thiếu máu của cơ thể.
Việc thực hiện đầy đủ các xét nghiệm này giúp bác sĩ không chỉ xác định mức độ giảm tiểu cầu mà còn tìm ra nguyên nhân chính xác, từ đó đưa ra phương pháp điều trị phù hợp, hạn chế nguy cơ chảy máu và các biến chứng nguy hiểm. Xét nghiệm toàn diện là bước quan trọng để bảo vệ sức khỏe người bệnh và hỗ trợ quản lý bệnh hiệu quả.
Xét nghiệm xuất huyết giảm tiểu cầu khi nào cần thực hiện? Dấu hiệu cảnh báo sớm
Xuất huyết giảm tiểu cầu là tình trạng lượng tiểu cầu trong máu giảm bất thường, làm tăng nguy cơ chảy máu dù chỉ gặp những va chạm nhẹ. Tiểu cầu đóng vai trò quan trọng trong quá trình đông máu, giúp cầm máu khi cơ thể bị tổn thương. Khi số lượng tiểu cầu giảm xuống dưới mức bình thường, các biểu hiện chảy máu dễ xảy ra, đôi khi có thể đe dọa tính mạng nếu không được phát hiện và xử lý kịp thời. Vì vậy, xét nghiệm xuất huyết giảm tiểu cầu là cần thiết để chẩn đoán chính xác, đánh giá mức độ nghiêm trọng và xác định nguyên nhân gây bệnh.
Dấu hiệu lâm sàng cần cảnh giác
Người bệnh mắc xuất huyết giảm tiểu cầu thường xuất hiện một số biểu hiện rõ ràng mà cả bệnh nhân và người nhà cần lưu ý:
- Xuất huyết dưới da: Đây là dấu hiệu phổ biến nhất, thường xuất hiện dưới dạng các chấm nhỏ li ti (petechiae), nốt xuất huyết, mảng bầm hoặc đám xuất huyết lan rộng. Các nốt xuất huyết có thể đa hình thái và đa màu sắc, từ đỏ, tím đến xanh vàng, phản ánh mức độ tổn thương mạch máu và sự giảm tiểu cầu.
- Chảy máu niêm mạc: Người bệnh có thể bị chảy máu chân răng, chảy máu mũi hoặc nôn ra máu. Ở nữ giới, tình trạng rong kinh bất thường hoặc kinh nguyệt kéo dài, máu ra nhiều cũng có thể là biểu hiện của giảm tiểu cầu.
- Rối loạn tiêu hóa liên quan máu: Phân có màu đen (tái xuất huyết tiêu hóa) là một dấu hiệu nghiêm trọng, cảnh báo chảy máu trong đường tiêu hóa cần được khám ngay.
- Gan, hạch ngoại vi: Khác với một số bệnh lý khác, trong xuất huyết giảm tiểu cầu, gan và hạch ngoại vi thường không to. Đây là điểm giúp phân biệt với các bệnh lý huyết học khác.
Khi nào cần thực hiện xét nghiệm?
Các dấu hiệu trên là cảnh báo để bệnh nhân chủ động đi khám và thực hiện xét nghiệm máu tổng phân tích tế bào ngoại vi, nhằm đánh giá số lượng tiểu cầu và các thành phần máu khác. Trong một số trường hợp, bác sĩ có thể chỉ định thêm xét nghiệm tủy đồ hoặc các xét nghiệm bổ sung để xác định nguyên nhân, phân biệt với các bệnh lý khác như nhiễm trùng, bệnh tự miễn, hay rối loạn huyết học.

Việc thực hiện xét nghiệm kịp thời không chỉ giúp chẩn đoán chính xác mà còn ngăn ngừa các biến chứng nguy hiểm, như chảy máu nội tạng, xuất huyết não hay suy đa cơ quan. Nhận biết sớm các dấu hiệu và chủ động xét nghiệm là bước quan trọng để bảo vệ sức khỏe, đặc biệt ở trẻ nhỏ, người cao tuổi hoặc những người có bệnh nền dễ gặp biến chứng.
Nhận biết sớm các dấu hiệu của xuất huyết giảm tiểu cầu và thực hiện các xét nghiệm cần thiết là bước quan trọng để bảo vệ sức khỏe. Xét nghiệm xuất huyết giảm tiểu cầu không chỉ giúp đánh giá số lượng tiểu cầu mà còn hỗ trợ bác sĩ xác định nguyên nhân gây bệnh, từ đó xây dựng phác đồ điều trị hiệu quả. Việc chủ động thăm khám và xét nghiệm kịp thời sẽ giảm thiểu nguy cơ chảy máu nghiêm trọng, bảo vệ cơ thể trước những biến chứng tiềm ẩn và duy trì chất lượng cuộc sống.
:format(webp)/470051785_8767135473405056_691967411107495592_n_6b2bbff755.png)
:format(webp)/467434554_545745841560409_1066418224364723785_n_560a494f9c.png)
/xet_nghiem_mau_phat_hien_lau_co_chinh_xac_khong_va_can_luu_y_gi_2_5e92f85218.png)
/xet_nghiem_gen_thalassemia_mat_bao_lau_va_khi_nao_co_ket_qua_349ef7821f.jpg)
/ure_trong_mau_cao_la_benh_gi_va_canh_bao_suc_khoe_can_biet_0_5ea50bbd33.png)
/chi_so_ct_la_gi_chi_so_ct_bao_nhieu_la_am_tinh_1_2e0f5fb47a.jpg)
/xet_nghiem_nse_de_lam_gi_khi_nao_nen_thuc_hien_xet_nghiem_dinh_luong_nse_1_453b4bc0ae.jpg)